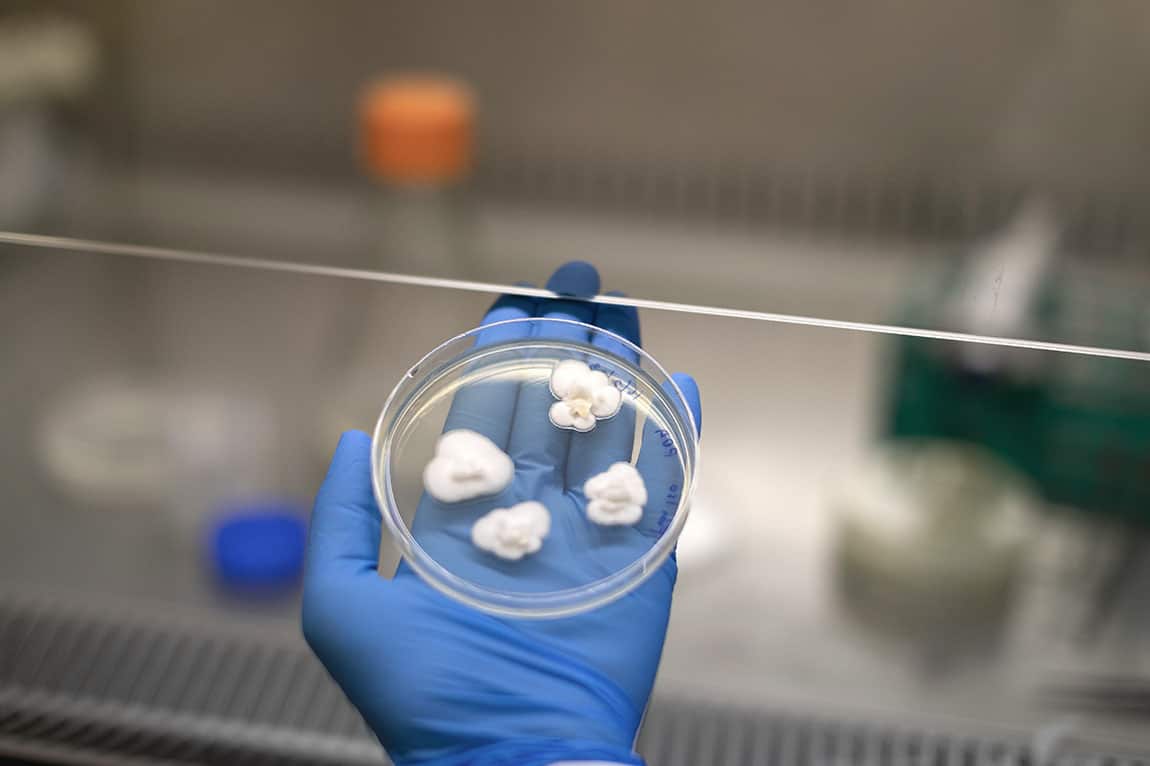
image003.jpg

Key Points
- A University of Sydney team has isolated two strains of fungi that can break down polypropylene, a major contaminant.
- The achievement came after three years of continuous research and rigorous testing.
- The fungi can biodegrade plastic by 27 per cent within 90 days.
Polypropylene is a common plastic used for a wide variety of products from packaging and toys to furnishing and hospital equipment and while it accounts for almost a third of global plastic waste, only one per cent of it is able to be recycled.
Now, in a major development, Australian Lebanese Professor Ali Abbas, who heads a research team at the University of Sydney, has discovered fungi that "eats" or breaks down plastic.
Professor Abbas said the team's tests had shown that within 90 days, the fungi were able to "eat" up to 27 per cent of plastic material which would otherwise take hundreds of years to break down in landfills or nature.
Published in journal "npj: Materials Degradation", two common strains of fungi were used to successfully biodegrade polypropylene in laboratory experiments.
Typically found in soil and plants, Aspergillus terreus and Engyodontium album were able to break down polypropylene after it had been pre-treated with either UV light or heat, reducing the plastic by 21 per cent over 30 days of incubation, and by 25-27 per cent over 90 days.

“Plastic pollution is by far one of the biggest waste issues of our time. The vast majority of it isn’t adequately recycled, which means it often ends up in our oceans, rivers and in landfill,” said Ms Samat in a university statement.
Ms Samat’s PhD supervisor, Professor Abbas from the School of Chemical and Molecular Engineering and Chief Circular Engineer at Circular Australia, said an estimated 109 million tonnes of plastic pollution was choking the world’s rivers and a further 30 million tonnes drifting in oceans.
"Despite the massive scale of plastic production and consumption, there has been very little attention paid to plastics degradation under environmental conditions, and our understanding of how plastics can be degraded is limited,” he said.
“One big question our result has raised is: what are the naturally occurring conditions which can fast track the degradation of plastics? We seek to further explore the role of biological processes offered by fungi and other microorganisms.”

As part of the team's experiments, polypropylene in various forms was initially treated with one of three separate methods: UV light, heat, and Fenton’s reagent – an acidic solution of hydrogen peroxide and ferrous iron often used to oxidise contaminants.

In a petri dish, the fungi were applied separately as single cultures to treated polypropylene. The validity of the biodeterioration was then confirmed through microscopy techniques.
While the research didn’t evaluate how the plastic was degraded by the fungi or whether it was metabolised, the researchers say they hope to conduct further research to determine the type of biochemical processes taking place.
Professor Abbas told SBS Arabic24 that, “this research we conducted in our laboratories at the University of Sydney relates to the dismantling of plastic waste, especially polypropylene."
"This type of plastic is known to be very difficult to recycle because it is often used in food containers and when it goes to landfill, it contains plastic and is also contaminated with food waste,” he added.
Professor Abbas pointed out that this achievement was a breakthrough because plastic is currently one of the biggest environmental problems facing the world.
Did you like the article? Listen to the “Australia Today” program from Monday to Friday from 3pm to 6pm AEST via digital radio and the Radio SBS app available free of charge at Apple and Android.
Complete the interview on our Facebook, Twitter and Instagram accounts.




